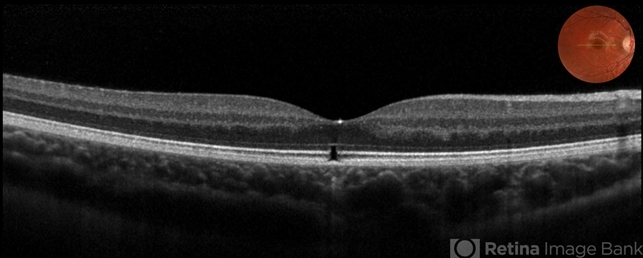
file

-
 By Bastián Schmidt Arias
By Bastián Schmidt Arias
Universidad Austral de Chile - Uploaded on Apr 28, 2019.
- Last modified by Caroline Bozell on Apr 30, 2019.
- Rating
- Appears in
- Miscellaneous
- Condition/keywords
- maculopathy, laser pointer maculopathy, optical coherence tomography (OCT)
- Photographer
- Bastian Schmidt
- Imaging device
-
Optical coherence tomography system
Topcon 3D OCT-2000 - Description
- Optical coherence tomography of a 13-year-old adolescent with a laser pointer maculopathy, 20/20 visual acuity with paracentral scotoma.

Initializing download.
Initializing download.










